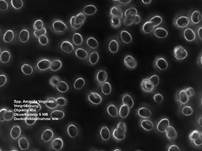

![]() Grauer
Scheidenstreifling, Grauer Streifling, Graubrauner Scheidenstreifling, Ringloser Wulstling,
Weißer Scheidenstreifling ESSBAR!
Grauer
Scheidenstreifling, Grauer Streifling, Graubrauner Scheidenstreifling, Ringloser Wulstling,
Weißer Scheidenstreifling ESSBAR! ![]()
AMANITA VAGINATA (SYN. AMANITOPSIS VAGINATA VAR.
VIOLACEA, AMANITA VAGINATA SUBSP. PLUMBEA)
|
|
|
|
|
Bilder oben 1+3 von links: Dieter Wächter (Thiersheim)
© Bilder oben 2 und unten 4 von links:
Franz Olloz (Schweiz - 4234 Zullwil) © Bild unten 5 von links: Josef Rösler
(Hausham) ©
Bilder oben 1-3 von links: Rudolf Wezulek ©
|
Eigenschaften,
Erkennungsmerkmale, Besonderheiten, (Gattungen): |
|||
|
Geruch: |
Unbedeutend, neutral, nicht marzipanartig. |
||
|
Geschmack: |
Mild, nussig, roh wie alle Scheidenstreiflinge unbekömmlich (giftig). |
||
|
Hut: |
3-8 (10) cm Ø, jung fast weiß, hellgelblich, später grau, graubraun mit
starken Rillen (Riefung) des Hutrandes von ca. 1/3 des Hut-Radiuses.
Bisweilen mit hellgrauen, häutigen Velumresten. |
||
|
Fleisch: |
Weiß, gelblich. |
||
|
Stiel: |
7-10 (11) cm lang, 6-12 (15) mm Ø dick, weißlich, hellgrau, kahl bis flockig
faserig, teils genattert, nach oben verjüngt, hohl, brüchig, Scheide: Weiß,
selten grau bis hell graubraun, nicht genattert. Die Basis ist schwach
verdickt, niemals knollig, Volva weißlich. Spitze ist leicht vom Hutfleisch
abtrennbar. |
||
|
Lamellen: |
Weiß, cremefarben, Scheide weiß ohne Verfärbungen. |
||
|
Sporenpulverfarbe: |
Weiß (8,5-12 x 8-11 µm, rundlich, Q = 1,1, Basidien viersporig,
Schnallen fehlen, Subhymenium-Zellen dünnwandig, in der Volva Sphaerozyten
nicht vorhanden, Marginalzellen Lamellenschneiden blasig-kugelig ca. 60 x 50
µm). |
||
|
Vorkommen: |
Mischwald, bei Nadel- und Laubbäumen, gern bei Eichen oder Kastanien, Mykorrhiza-Pilz
(Symbiosepilz) wie alle Scheidenstreiflinge, gesellig weit auseinander
wachsend, Frühjahr bis Herbst. |
||
|
Gattung: |
Scheidenstreiflinge. |
||
|
Verwechslungsgefahr: |
Ockergrauer
Scheidenstreifling, eine Varietät der Erlenstreifling, Grauhäutiger Scheidenstreifling,
Silber-Scheidenstreifling,
Schneescheidenstreifling
(AMANITA
NIVALIS). |
||
|
Besonderheit: |
Scheidenstreiflinge sind alle essbar, roh jedoch giftig. Wegen Verwechslungsgefahr mit Knollenblätterpilzen
sollten sie nur von Kennern gesammelt werden!
Die
wichtigsten Erkennungsmerkmale von Scheidenstreiflingen: Keine Kindersöckchen, d. h. heller Warzengürtel serpentinenartig
nach oben laufend (Pantherpilz)! Keine Knolle. Unter der Volva/Scheide an der Stielbasis befindet sich
keine Knolle! Keine vollkommen reinweißen Lamellen, mehr einen leichten Warmton. Kein Warzengürtel (Perlpilz,
Fliegenpilz). Keine Zwiebelknolle (Knollenblätterpilze – grüner, weißer …). Kein Aasgeruch (Tierkäfig - Zoo) (Knollenblätterpilze
– grüner, weißer). Kein Kartoffelkellergeruch (Gelber Knollenblätterpilz, Porphyrbrauner
Wulstling). Kein Rettichgeruch (Pantherpilz). Kein Ring. Kein süßlicher Geruch (Kegelhütiger Knollenblätterpilz, jung grüner oder weißer
Knollenblätterpilz). Lappige, schnell flüchtige Scheide. Milder Geschmack. Relativ weiches Fleisch, weicher Stiel, im Alter hohler Stiel. Schlanke, dünne Stielbasis. Starken Rillen (Riefung) des Hutrandes von ca. 1/3 des Hut-Radiuses. Die lappige Scheide und die fehlende Knolle sind die wichtigsten
Merkmale, weswegen Scheidenstreiflinge nur mit ausgegrabener Stielbasis
bestimmt werden sollten. |
||
|
Knollenform: |
|
||
|
Kommentar: |
Scheidenstreiflinge sind immer willkommene, gut schmeckende Speisepilze
- leider etwas brüchig! Transporttipp! Große Scheidenstreiflinge lassen sich fast
unbeschadet im Korb nach Hause bringen, wenn man die bereits ausgebreitete
Kappe sogleich abschneidet und diese zwischen Huflattichblätter oder anderes
größeres Laubzeugs (Farn, Pestwurz oder Ähnliches) legt. |
||
|
Relativer Speisewert: |
DGfM: Positivliste Speisepilz; 123pilze: Relative Wertigkeit 2. |
||
|
Wiki-Link: |
|||
|
Priorität: |
1 |
||
|
|
|
|
Bilder oben
6+7 von links: Dieter Wächter (Thiersheim) ©
Fotos oben 1-4 von
links: Rudolf Wezulek (Rudi) Klosterneuburg - Österreich © Fotos oben 5-7 von links:
Gerhard Koller ©
|
|
|
|
Bilder oben 1-3 von links: Helmut Hegewald
(Zittau) ©
Vorsicht vor
Pantherpilze, die haben gerne einen gerieften Hutrand!
|
TÖDLICH GIFTIG: Pantherpilz! |
Weitere Bestimmungshilfen und Informationen
hier:
|
|
|
|
|
|
|
Letzte Aktualisierung dieser Seite: Samstag, 15. November 2025 - 19:17:59 Uhr